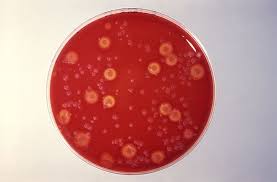

혈액순환이 원활하지 않으면 손발 저림, 피로감, 냉증 등의 증상이 나타날 수 있습니다. 이를 개선하기 위해 혈액순환 개선제를 사용하는 경우가 많습니다.
하지만 효능과 함께 주의사항을 정확히 알고 복용하는 것이 중요하며, 무분별한 사용은 오히려 부작용을 유발할 수 있습니다.
1. 💊 혈액순환 개선제 효능
혈액순환 개선제는 혈관을 확장시키거나 혈류를 원활하게 만들어 말초 혈액순환을 돕는 역할을 합니다.
손발 저림, 냉증, 피로 개선에 도움이 될 수 있습니다.
- 💊 혈류 개선
- 🖐️ 손발 저림 완화
- ❄️ 냉증 개선
- 😌 피로 감소
2. ⚠️ 복용 시 주의사항
혈액순환 개선제는 혈액 응고에 영향을 줄 수 있기 때문에 특정 질환이 있는 경우 주의가 필요합니다.
특히 항응고제 복용 중이거나 수술 예정이 있는 경우 전문가 상담이 필요합니다.
- ⚠️ 출혈 위험 증가
- 💊 약물 상호작용
- 🩺 전문가 상담 필요
3. 🔍 주요 성분 종류



대표적인 성분으로는 은행잎 추출물, 오메가3, 비타민 E 등이 있으며 각각 혈류 개선에 도움을 줍니다.
성분에 따라 효과와 특징이 다르기 때문에 선택 시 확인이 필요합니다.
- 🌿 은행잎 추출물
- 🐟 오메가3
- 💊 비타민 E
4. 🛠️ 복용 방법
정해진 용량과 복용 방법을 지키는 것이 중요합니다. 과다 복용은 부작용을 유발할 수 있습니다.
식사 후 복용하는 것이 위장 부담을 줄이는 데 도움이 됩니다.
- 🛠️ 정량 복용
- 🍽️ 식후 복용 권장
- ⚠️ 과다 복용 금지
5. 🛡️ 함께 관리해야 할 습관
약물만으로는 충분하지 않으며 운동과 식습관 개선이 병행되어야 합니다. 특히 규칙적인 운동은 혈액순환 개선에 매우 중요합니다.
생활습관 개선이 효과를 높이는 핵심입니다.
- 🏃 규칙적인 운동
- 🥗 건강한 식단
- 🚫 흡연 제한
- 💧 충분한 수분 섭취
6. 📊 전체글 요약표
혈액순환 개선제는 올바르게 사용해야 효과를 볼 수 있습니다.
| 항목 | 내용 |
|---|---|
| 💊 효능 | 혈류 개선 |
| ⚠️ 주의 | 출혈 위험 |
| 🔍 성분 | 은행잎, 오메가3 |
| 🛠️ 복용 | 정량 복용 |
| 🛡️ 관리 | 생활습관 개선 |
7. ❓ 자주 묻는 질문
Q1. 누구나 복용해도 되나요?
A1. 일부 질환이 있으면 주의가 필요합니다.
Q2. 효과는 언제 나타나나요?
A2. 개인차가 있으며 꾸준한 복용이 필요합니다.
Q3. 부작용이 있나요?
A3. 출혈 위험이나 소화불편이 있을 수 있습니다.
Q4. 음식으로 대체 가능한가요?
A4. 일부 가능하지만 보충이 필요할 수 있습니다.
Q5. 가장 중요한 점은 무엇인가요?
A5. 생활습관과 병행하는 것입니다.
8. 🧾 결론 – 올바른 복용과 생활관리 병행이 중요합니다
혈액순환 개선제는 보조적인 수단이므로 올바른 복용과 함께 운동, 식습관 개선을 병행해야 효과를 높일 수 있습니다.

'건강' 카테고리의 다른 글
| 관절염에 좋은 음식ㅣ먹는방법ㅣ효능ㅣ주의사항 (0) | 2026.04.22 |
|---|---|
| 무릎 연골 손상 증상ㅣ원인ㅣ치료법 (0) | 2026.04.22 |
| 말초신경병 증상ㅣ원인ㅣ치료법ㅣ주의사항 (0) | 2026.04.21 |
| 귀에서 심장박동소리ㅣ원인ㅣ꼭 이렇게 하세요 (0) | 2026.04.21 |
| 저혈당 쇼크 증상ㅣ대처방법ㅣ주의사항 (0) | 2026.04.20 |



